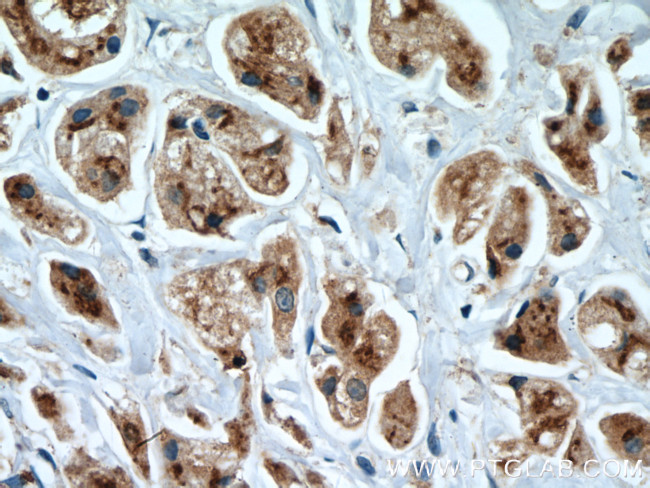
SGSM3 Antibody in Immunohistochemistry (Paraffin) (IHC (P))

Search
Proteintech
SGSM3 Polyclonal Antibody
{{$productOrderCtrl.translations['antibody.pdp.commerceCard.promotion.promotions']}}
{{$productOrderCtrl.translations['antibody.pdp.commerceCard.promotion.viewpromo']}}
{{$productOrderCtrl.translations['antibody.pdp.commerceCard.promotion.promocode']}}: {{promo.promoCode}} {{promo.promoTitle}} {{promo.promoDescription}}. {{$productOrderCtrl.translations['antibody.pdp.commerceCard.promotion.learnmore']}}
产品信息
27147-1-AP
种属反应
宿主/亚型
分类
类型
抗原
偶联物
形式
浓度
规格
纯化类型
保存液
内含物
保存条件
运输条件
产品详细信息
Immunogen sequence: MSGSHTPAC GPFSALTPSI WPQEILAKYT QKEESAEQPE FYYDEFGFRV YKEEGDEPGS SLLANSPLME DAPQRLRWQA HLEFTHNHDV GDLTWDKIAV SLPRSEKLRS LVLAGIPHGM RPQLWMRLSG ALQKKRNSEL SYREIVKNSS NDETIAAKQI EKDLLRTMPS NACFASMGSI GVPRLRRVLR ALAWLYPEIG YCQGTGMVAA C (1-210 aa encoded by BC008078)
靶标信息
May play a cooperative role in NF2-mediated growth suppression of cells. [UniProt]
仅用于科研。不用于诊断过程。未经明确授权不得转售。
篇参考文献 (0)
生物信息学
蛋白别名: Cx43-interacting protein of 85-kDa; dJ1042K10.2; DKFZp761D051; MAP; merlin binding protein; Merlin-associated protein; Rab-GTPase-activating protein-like protein; RabGAP-5; RabGAPLP; RUN and SH3 containing 3; RUN and TBC1 domain containing 3; RUN and TBC1 domain-containing protein 3; sgsm3; Small G protein signaling modulator 3; small G protein signaling modulator 3 protein; unnamed protein product
基因别名: 1810012I01Rik; AI428557; BB175482; CIP85; MAP; R75178; RabGAP-5; RABGAP5; RABGAPLP; RUSC3; RUTBC3; SGSM3
UniProt ID: (Human) Q96HU1, (Mouse) Q8VCZ6
Entrez Gene ID: (Human) 27352, (Mouse) 105835